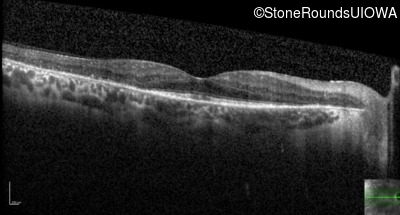
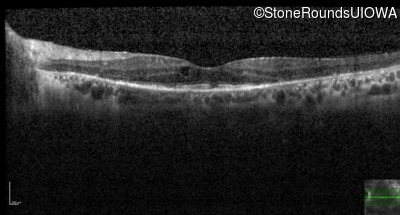
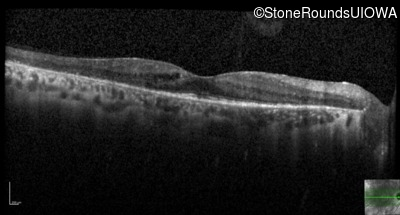
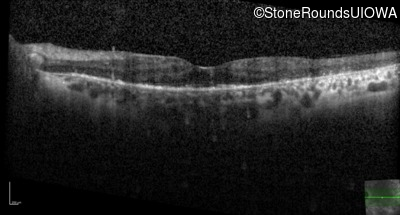
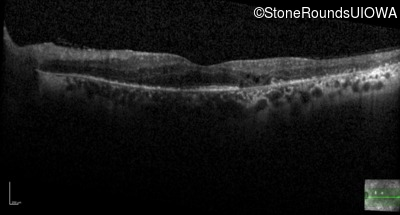
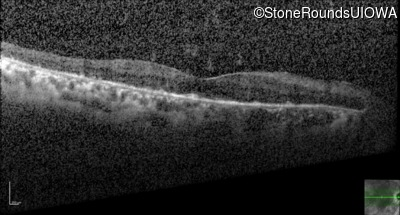
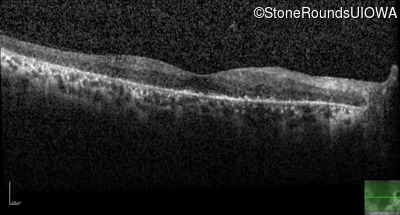
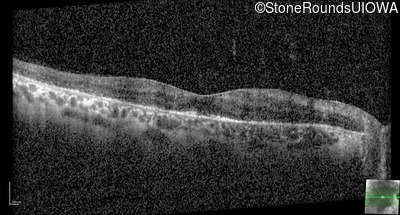
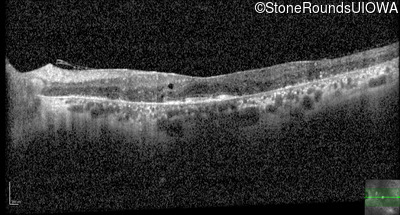
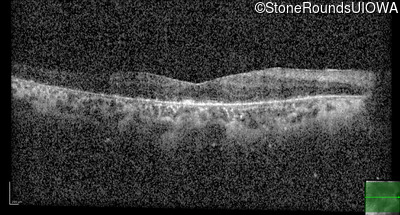

Case
SR190
Student Mode
AD Retinitis Pigmentosa (IA1aii)
Female
Female
Hidden
SR190
Student Mode
AD Retinitis Pigmentosa (IA1aii)
Female
Female
History
This 53 year old woman first came to attention when she had difficulty walking down stairs. A few years later she noticed difficulty seeing in dim light.
| Age at visit: 53 years |
| Age at visit: 60 years |
| Age at visit: 62 years |
| Age at visit: 63 years |
| Age at visit: 65 years |
Diagnosis & molecular findings
| Disease | Gene | Allele 1 variant(s) | Allele 2 variant(s) | Inheritance mode |
|---|---|---|---|---|
| AD Retinitis Pigmentosa | PRPH2 | Pro216Ser CCT>TCT | AD |